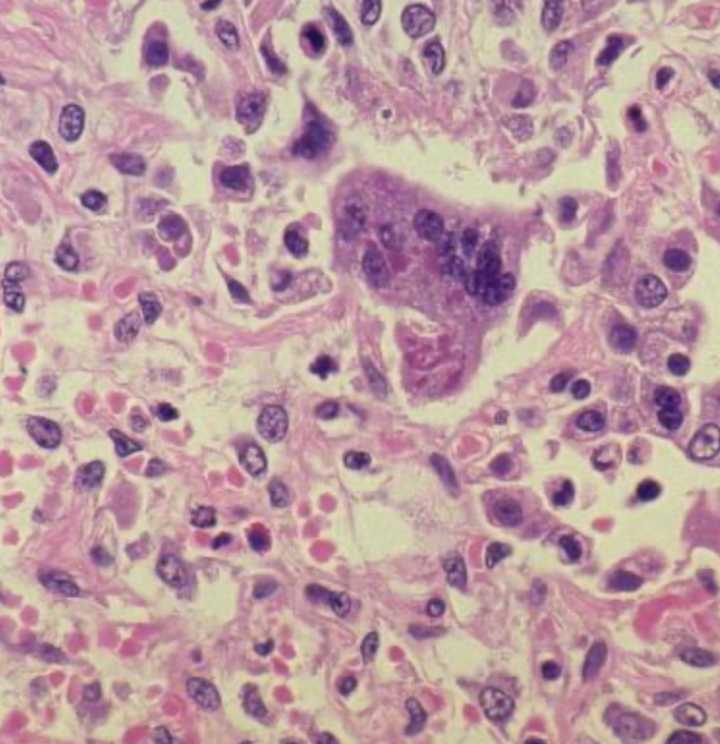

An unvaccinated child in Olmsted County has contracted measles, leading officials to urge vaccination against the contagious illness.
On Friday, Olmsted County Public Health Services announced that a child under the age of five had a confirmed case of measles and was exhibiting symptoms.
The child, who was unvaccinated against the virus that causes the disease, had recently traveled internationally, according to the office. OCPHS says it is working with the Minnesota Department of Health to contact those who were exposed to the child.
According to data from MDH, last updated on Oct. 9, a total of 20 measles cases have been reported in the state in 2025.
Measles symptoms include fever, cough, runny nose, and watery eyes, followed by a rash that is known is spread from the head to the re

 Bring Me The News
Bring Me The News
Las Vegas Sun
Las Vegas Sun Deseret News
Deseret News Tribune Chronicle Community
Tribune Chronicle Community CNN Health
CNN Health People Human Interest
People Human Interest News 5 Cleveland
News 5 Cleveland Sacramento Observer
Sacramento Observer Associated Press US and World News Video
Associated Press US and World News Video Aljazeera US & Canada
Aljazeera US & Canada KCRA News
KCRA News America News
America News